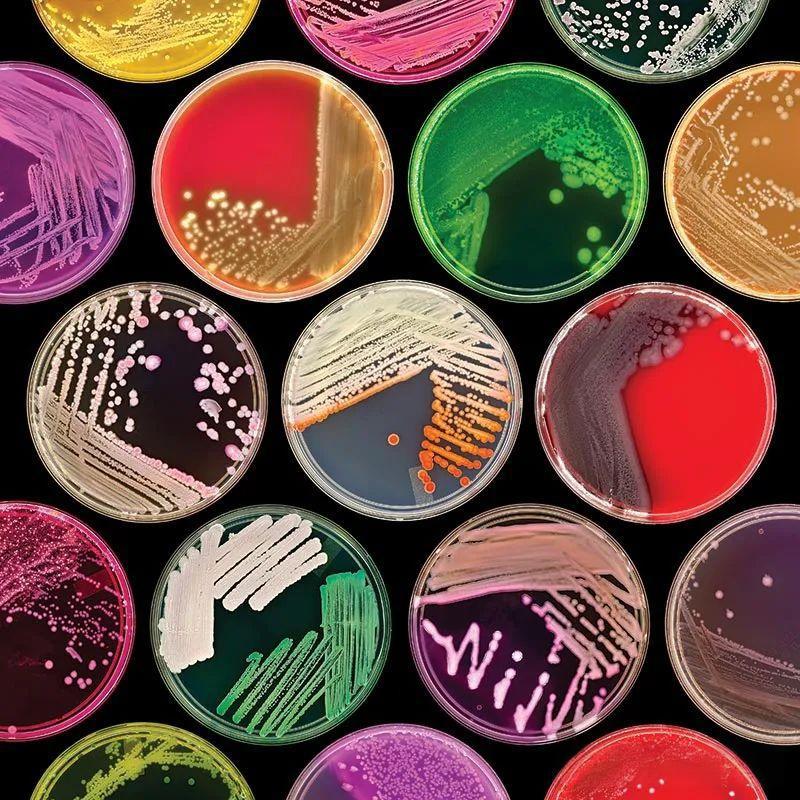
1.jpeg

1 实验背景
细菌培养被广泛应用于生物化学与分子生物学的实验,例如基因克隆与表达、DNA与RNA的提取、酶的生产、细菌与细胞共培养等。下面以基因克隆表达中大肠杆菌(生长周期短)的培养、鸟分枝杆菌(生长周期长)的培养为例分享主要的实验步骤和注意事项:
2 实验步骤
2.1 准备工作
(1)培养基准备:LB培养基(大肠杆菌)、Middle brook培养基(鸟分枝杆菌)
(2)试剂准备:蛋白胨、酵母提取物、氯化钠、琼脂、购买Middle brook 7H10固体培养基和Middle Brook 7H9肉汤培养基、蒸馏水、抗生素(氨苄青霉素、羧苄青霉素、两性霉素B)、购买增菌液。
(3)仪器、耗材准备:细菌培养皿、50mL无菌离心管、试管、锥形瓶、接种环、酒精灯、打火机、高压蒸汽灭菌锅、37℃恒温培养箱、生物安全柜、超净工作台、恒温摇床。
2.2 实验步骤
(1)灭菌:按照下面成分(见表1)配置培养基,使用高压蒸汽灭菌法121℃、30min进行灭菌处理。接着将准备的细菌培养皿、50mL无菌离心管、锥形瓶、接种环、酒精灯等物品放置在超净工作台打开紫外线照射至少30min。
(2)培养基配置比例:培养基的配置需要按照质量比例要求例如LB培养基需按照质量(g)比(2:1:2)分别称取蛋白胨、酵母提取物、氯化钠,购买的分枝杆菌培养基按照说明书根据使用的量进行配置。固体培养基的配置加入琼脂粉一般按照15.0 g/L的比例加入。

(3)倒平板:根据细菌的生长状况设置平板的厚度,培养基的量通常的大肠杆菌10mL/平板(培养基层厚度约3-4mm),而分枝杆菌需要20mL/平板(培养基层厚度约5-6mm)。
(4)活化、接种:菌种的来源可以是涂布的平板也可以是保存在-80℃的菌种。关闭紫外线,打开超净工作台通风,点燃酒精灯,将接种环放置在酒精灯上灼烧至红色,放置在火焰周围冷却。挑取适量菌落或者菌液进行划线,使得菌液以多至少的量(图1)分布在培养基表面。

(5)培养:可将处理好的培养基用封口膜封闭好,正置37℃恒温培养箱30min左右,然后倒置培养。
(6)观察:按照细菌的生长周期观察期生长状况,大肠杆菌一般需要12~16h,而分枝杆菌生长缓慢需要1~4周左右。
(7)液体培养:一般在活化、接种后,划线的平板长出清晰的单克隆菌落,此时我们可以挑取单菌落进行扩大培养。将液体培养基按15~20mL的量倒入无菌离心管或者10mL左右倒入试管,在灼烧接种环灭菌冷却后将菌落挑取伸入试管轻轻晃动,使菌落落入液体培养基,封口膜封闭试管或者离心管;最后放置恒温摇床进行培养。
3 注意事项
(1)细菌培养要求所涉及的物品、操作均要求无菌,否则会存在其他杂菌的污染。
(2)灭菌之前注意按照菌的生长情况调节培养基的pH值例如LB培养基要求PH值在7.0~7.4之间,防止偏酸或者偏碱的环境影响菌的生长。
(3)培养基配置时,使用蒸馏水充分溶解;灭菌完成后,固体培养基可以暂放烘干箱后倒平板。
(4)抗生素、增菌液一定是等待培养基稍稍冷却至手可以正常触碰锥形时加入,否则抗生素会失效。
(5)所使用的的物品基本上放置在酒精灯的周围,例如倒平板时,灼烧瓶口后一手操作平板一手操作锥形瓶倒平板(图2)。

(6)为了防止平板产生水汽,可以将平板半敞开在酒精灯周围,也可以全部叠放在酒精灯的旁边(图3)。

(7)分枝杆菌生长周期长,需要按照说明书的比例加入增菌液、抗生素以及倒厚平板,保证长时间的培养有足够营养成分和良好的生长环境。
(8)鸟分枝杆菌属于非结核分枝杆菌,存在一定的感染性,使用前需要用60℃水浴灭活30min,同时在生物安全柜中进行操作,防止感染。
(9)在实验操作过程中,需佩戴好手套、口罩、穿好实验服等。
(10)平板处理,有一定感染性的平板需要集中灭菌处理后再丢弃。
(11)注意标记平板,一般标记好时间、菌种名称、培养条件等。
细胞实验外包 想了解更多请关注:https://www.do-gene.cn/

